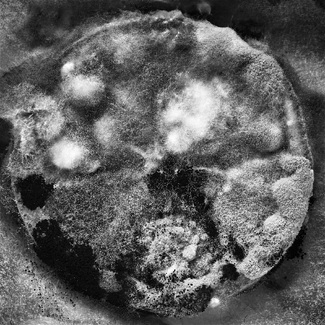

|
Marcus Hausser Brazil 1st Place - Outstanding Achievement "Hands" Man of Hands |
|
Lennette Newell USA 2nd Place - Merit of Excellence "Elephant Abstract" African Elephant Eye |
|
Beatrix Jourdan Hungary 3rd Place - Honor of Distinction "Dots" |
|
Paul Grand USA Honorable Mention "Steel Block Composition no.4" Antique steel blocks - New York 2016 |
|
Edoardo Romagnoli Italy Honorable Mention "2715" 11 august 2014, 23.31pm, the light of the moon tears the landscape, one shot, no post production |
|
Peter Arnold UK Honorable Mention "Midnight Dunes 1" Midnight Dunes Series |
|
Michel Merce Canada Honorable Mention "Butterfly Fingers" How to transform a man and his hand to a butterfly... |
|
Kevin Vandivier USA Honorable Mention "Cloud Lines" While flying to an assignment, I looked out the window to see these clouds all lined up as though they had been placed in an order. I’ve never seen anything like it. I grabbed my camera and shot a few frames. Upon on returning to my studio I performed my post production on the image and again was amazed at how these clouds just lined up so perfectly as if it was a field and Jesus had just planted them there in these rows. I felt that perhaps God was metaphorically telling me to plant His seeds in His fields, my translation…Love others as He has loved me. |
|
James A. Hudson UK Honorable Mention "3 Muses" Fashion story inspired by Plutarch’s ancient muses: Practice, Memory and Song. |
|
Susan Brunner Switzerland Honorable Mention "Alien (2)" |
|
Masahiro Ito Japan Honorable Mention "masquerade #5" Through something that we can't be seen in daily, I show that it's present in a place that doesn't seem true of the goodness of you. |
|
Tony Hertz USA Honorable Mention "Nature's Nude in Sandy Dunes" The Oceano sand dunes reveal an idyllic and eerie-like nude figure. |
|
Jackie Ranken New Zealand Honorable Mention "Driveby" Driveby capture from the passenger seat. |
|
Bowman Ashe USA Honorable Mention "Blades" |
|
Dan Yang Wu Taiwan Honorable Mention "Fantasy Earth1" 2016Taipei |
|
matt stock USA Honorable Mention "Man-O-War" Close up of the tentacle structure of a man-o-war photographed in a tank in my studio. |
|
Ross Deverson Canada Honorable Mention "The Train" Where: Jakarta, Indonesia. About: A train leaving the station |
|
Sacha Ineichen Switzerland Honorable Mention "Flow2" sea grass |
|
Ron Schwager USA Honorable Mention "Futurism" Our environmental engineers and architects are creating evolving forms. Buldings are becoming interesting shapes. This is an example juxtaposed with gracefully rolled paper. |
|
Alexandre Manuel Portugal Honorable Mention "Abstract Landscape Study 1" Bamboo sticks on a seaweed farm, China |
|
Nirzhar Pradhan USA Honorable Mention "0_Rising 01" From the series, "Rising, Falling". An attempt at looking deeper into the present moment. |
|
Sidney Cheung Hong Kong Honorable Mention "Airport" |
|
Adolfo Enriquez Calo Spain Nominee "Geometric" |
|
Alan Skyrme Brazil Nominee "Door, Bahrain" Detail of a wooden door handle, Bahrain |
|
Alexandre Manuel Portugal Nominee "Volcanic Rivers" aerial view from a cessna plane to the icelandic rivers |
|
Aloisi Gioia Gorini Monica Italy Nominee "Birds" incredible graffiti on the facade of a building in Milan . Suddenly, the city has become a small vi |
|
Andre Boto Portugal Nominee "Lines (1)" Just two spoons... |
|
Ankit Nandwani India Nominee "Starry Night" |
|
Ann Elliott Cutting USA Nominee "Water Drops" Water Drop Collision |
|
Anna Wloch Poland Nominee "Demonstration" Poland |
|
Anna Kadykova Russia Nominee "Insight" |
|
Annette Willis Australia Nominee "Multiple Effects of Reflection" Part of a series taken from my iPhone journal of daily life. |
|
Barbara Warren USA Nominee "Untitled (2)" |
|
Bowman Ashe USA Nominee "Puff" |
|
Carol Sharp UK Nominee "Transmutation I" |
|
Cathrin Schulz South Africa Nominee "[Un]Domesticated, Silent Scream (1)" A project with animal handler Luke Cornell and his wild animal sanctuary. South Africa, 2014. |
|
Cathrin Schulz South Africa Nominee "[Un]Domesticated, Silent Scream (2)" A project with animal handler Luke Cornell and his wild animal sanctuary. South Africa, 2014. |
|
Chou Fang Yu Taiwan Nominee "Untitled (1)" |
|
Christian Mushenko Australia Nominee "Perspective vs View" We all view the world framed by our past and filtered by our experience |
|
Christina Czybik Germany Nominee "Abstract Downtown LA" One Exposure of the View on Downtown Los Angeles |
|
Christina Schmidhofer USA Nominee "Water Study 2" water study series |
|
Christina Schmidhofer USA Nominee "Space H2O 2" Space |
|
Christopher Brown USA Nominee "Dancing on Water" 4x5 Large Format Film |
|
Christopher Brown USA Nominee "Study of Light" 4x5 Large Format Film |
|
Clayton Bastiani UK Nominee "Bokeh" |
|
Dan Yang Wu Taiwan Nominee "An Abstract Eye" 2016Taipei |
|
Dan Yang Wu Taiwan Nominee "Fantasy Earth3" 2016Taipei |
|
Danielle Austen USA Nominee "Serpent's Breath" Long exposure on the Little Pigeon River, Greenbrier, Great Smoky Mountains National Park, TN. |
|
Danielle Austen USA Nominee "Raven" Long exposure of tidal waters at Schoodic Pennsula, Acadia National Park, ME. |
|
David Filiberti USA Nominee "Liquid Study #4" This is a study of the various forms that liquid takes in an airborne state. |
|
David Filiberti USA Nominee "Liquid Study #5" This is a study of the various forms that liquid takes in an airborne state. |
|
Deniz Saylan Germany Nominee "Dancing Against the Wall" |
|
Dunja Dumanski USA Nominee "Astronauts & Indians Hanging Piece" Collaboration of Small Green Door and Astronauts & Indians |
|
Duschan Tomic Italy Nominee "The Fan" Part of a series of cacti photographs while in Apulia, Italy |
|
Duschan Tomic Italy Nominee "Aloe" Part of a series of cacti photographs while in Apulia, Italy |
|
Edoardo Romagnoli Italy Nominee "Monte Bianco 6808" 2015-09-25-00.49am,Monte Bianco,the light of three moon on the top of Monte Bianco,no postproduction |
|
Ellen Jantzen USA Nominee "In The Cold Light of Night" From my Unity of Time and Place series |
|
Ellen Jantzen USA Nominee "Negative Dreaming" Negative Dreaming |
|
Florian W. Mueller Germany Nominee "Crumble in the Woods" Minimalistic multilayer photography of a forest in northern Sweden. |
|
Gillian Lindsay Canada Nominee "Introspection" Light Imitating Art series |
|
Gillian Lindsay Canada Nominee "Light Flow" Light Imitating Art series |
|
Harvey Duze USA Nominee "Graffiti Railroad Bridge #2" Graffiti covered Susquehanna Division Railroad Bridge near Port Deposit, MD, across Octoraro Creek. |
|
Helen Zakhtser Russia Nominee "Pattern 2" |
|
Hiroyasu Matsui Japan Nominee "Single-Slit Experiment 05" This work is using a lens an 0.5mm slit was prepared using two razor blades. |
|
James Fox USA Nominee "Abstract 2" Mist from Morning Glory pool in Yellowstone NP |
|
James Fox USA Nominee "Abstract !" Grass and tree parts |
|
Janice Tieken USA Nominee "Black Cloud Strike" A contrail, a cloud and many lines crossing |
|
Jean Rouzaud France Nominee "H2O Atom Heart Mother" Block of ice with projector and 4 symmetries. Strange life form appear. |
|
Jiri Tondl Czech Republic Nominee "Night Street" New Year's decoration of streets |
|
Jonathan Banks UK Nominee "Penrose Stairs 2" Looking up a stair well with a mirror ceiling giving the illusion that we are looking down |
|
Julien Manigand France Nominee "Textures of Time " Textures of Time - Ice |
|
Juliet Harrison USA Nominee "Whose Reality?" Shot on 35mm film. |
|
Karen Steenwinkel Netherlands Nominee "Tulips in the Night" A different perspective on the most colorful part of the Netherlands |
|
Kentaro Sekine Japan Nominee "Siberia" The image reminds me of Siberia from a view on board. Taken in Hokkaido, Japan. |
|
Kingsley Burton Australia Nominee "Liberum Solveret" I have waited 20 years to take this photograph |
|
Kingsley Burton Australia Nominee "Alligators in New York" Reflections in New York |
|
Kristofer Dan-Bergman USA Nominee "I Can See U" This is one photograph from my "Bridges to Manhattan" series |
|
Laurie Rhodes USA Nominee "July 4th Fireworks" Photograph of fireworks through a screen window |
|
Lennette Newell USA Nominee "Natural Impression" composite of tree reflection landscape |
|
Leonard Butusina Romania Nominee "Limits" Peace |
|
Louis Gaillard France Nominee "Shadow" |
|
Lucy A Kennedy USA Nominee "At My Feet" Sands of the Pacific. |
|
Lucy A Kennedy USA Nominee "Behind CVS" This is a garage in Vegas! |
|
Madiha Abdo UK Nominee "Highway" |
|
Madiha Abdo UK Nominee "Parallel Lines" |
|
|
Manuel Correia Portugal Nominee "Slit" Aerial Photograph of Maranhão, Brazil |
|
Marg Navratil USA Nominee "Class Time" |
|
Mark Kelly Australia Nominee "Tree Ghosts IV" |
|
Masahiro Ito Japan Nominee "masquerade #1" Through something that we can't be seen in daily, I show that it's present in a place that doesn't seem true of the goodness of you. |
|
|
Michael Shapiro USA Nominee "Reflection I" Oosterpark, Amsterdam 2016 |
|
Michael McLaughlin Ireland Nominee "Sleeping Dragon" The Sleeping Dragon lies dormant within the badlands at Death Valley |
|
Michel Merce Canada Nominee "Seahorse Sarah" Metamorphosis#66 Thousands times the same portraits |
|
Michele Abriola Italy Nominee "Trace" ILFORD DELTA400 FILM - "USA28" street photography series |
|
Nancie Battaglia USA Nominee "CarWash" Car Wash View |
|
Norma van der Horst Netherlands Nominee "IJsselmeer" Ship sailing with heavy weather on the IJsselmeer, Netherlands |
|
Oksana Moroziuk Russia Nominee "Lines (2)" |
|
Patrick van Dam Singapore Nominee "Summer" |
|
Paul Sanders UK Nominee "Line and Light" |
|
Pete McCutchen USA Nominee "Dark Waves 2" |
|
Pooyan Tabatabaei Canada Nominee "Interview with a Ghost" famous Sound Engineer lost his fame in a new country. Here, he is just a hand to bring food on the table for his family; with lots of good memories |
|
Roberto Soares-Gomes Brazil Nominee "w_Abstract" Hamburg, Germany. |
|
Roberto Pastrovicchio Italy Nominee "Mould" It happens you forget an orange slice somewhere, after all the result is amazing. |
|
Ross Thompson Australia Nominee "Monstereo" Unfurling Monstereo Deliciosa leaves. |
|
Ross Deverson Canada Nominee "Through" Where: Brighton, U.K. About: View of the sea |
|
Sacha Ineichen Switzerland Nominee "Flow1" sea grass |
|
Sebahat Ersoy Turkey Nominee "Sad Cycle of Life" |
|
Sebahat Ersoy Turkey Nominee "Seed for a New Life" |
|
Sebahat Ersoy Turkey Nominee "We Are All in the Same Boat III" There are no winners in war, only losers. The boat is a metaphor for the world. Shadows symbolize war supporters. Children who died in the sinking of the boat symbolize the refugees. |
|
Sharon Packer USA Nominee "Dandelions" |
|
Simon Puschmann Germany Nominee "Bathroom Wall in a Flat, London" |
|
Steven Edson USA Nominee "Road Paint" White road stripe painted on black asphalt. |
|
Thomas Nero USA Nominee "when they move #6657" |
|
Thomas Nero USA Nominee "when they move #9647" |
|
Tom Epperson Philippines Nominee "Cranes" |
|
Ton Dirven Netherlands Nominee "Mushroom" tondirven |
|
|
Vera Regina Bandeira Brazil Nominee "Sem TÃtulo" |
|
Vinicius Nakashima Brazil Nominee "18 Percent" Color digital photography that seeks to suscitate the visual experience of color apprehension limits. Plant and spray paint without image manipulation. |
|
Yoshiteru Yamamoto Canada Nominee "Lost Shoe" Find the Lost Shoe |
< back




































![[Un]Domesticated, Silent Scream (1) [Un]Domesticated, Silent Scream (1)](../magicimage.php?img=/home/thespiderawards/public_html/uploads/388393/20/388393_Cathrin_Schulz_SilentScream_Grayscale.jpg&img_size=325)
![[Un]Domesticated, Silent Scream (2) [Un]Domesticated, Silent Scream (2)](../magicimage.php?img=/home/thespiderawards/public_html/uploads/388393/20/388393_Cathrin_Schulz_SilentScreams_Grayscale.jpg&img_size=325)